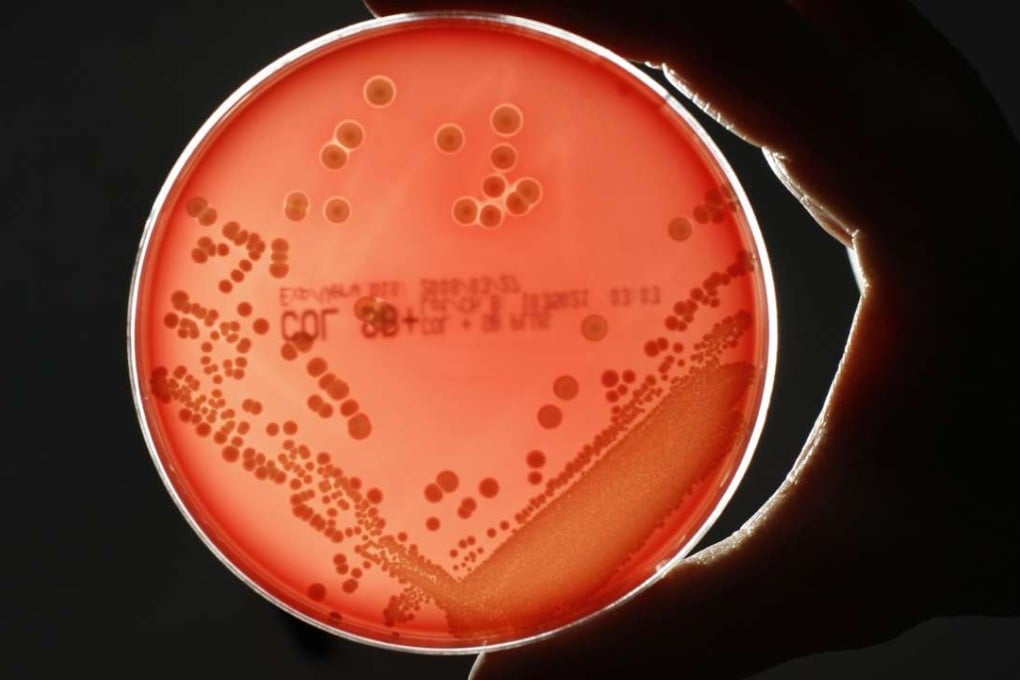
MRSA (Methicillin-resistant Staphylococcus aureus) bacteria is seen in a petri dish in a microbiological laboratory in Berlin, Germany. Photo: Reuters

Cheap blood test may distinguish viral and bacterial infections, preventing overuse of antibiotics
An inexpensive blood test could one day tell doctors whether an infection is caused by a virus or a bacteria, and help prevent unwarranted prescribing of antibiotics, which are useless in treating viral infection, researchers said Wednesday.
The diagnostic test, described in the peer-reviewed journal Science Translational Medicine, is being developed by the Stanford University School of Medicine in California.
“A lot of times you can’t really tell what kind of infection someone has,” said lead author Timothy Sweeney, an engineering research associate with the Stanford Institute for Immunity, Transplantation and Infection.
“If someone comes into the clinic, a bacterial or a viral infection often looks exactly the same.”
The new test, which is not yet on the market, works by identifying seven human genes whose activity changes during an infection, and whose pattern of activity can reveal whether an infection is bacterial or viral.
“Many diagnostics focus on trying to find bacteria in the bloodstream, but most infected people don’t have bloodstream infections, meaning such tests aren’t helpful,” Sweeney said.